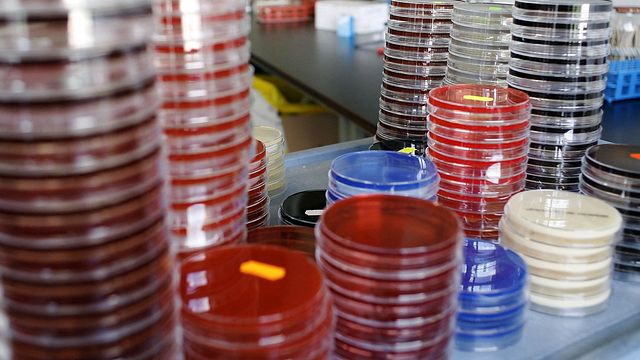

I medici ospedalieri hanno un'arma in più per combattere le infezioni multiresistenti, un problema crescente a fronte del quale la disponibilità di farmaci è stata fino ad oggi molto limitata. Dopo l'approvazione da parte dell'Agenzia italiana del Farmaco (Aifa), avvenuta a giugno 2021, è ora disponibile per la cura dei pazienti un antibiotico di nuova generazione in grado di combattere con efficacia i più temuti superbatteri: Cefiderocol.
La nuova cefalosporina utilizza un meccanismo di ingresso cellulare unico che, come un 'cavallo di Troia', è in grado di bypassare le principali barriere di resistenza.
"Ogni anno in Europa - ricorda Pierluigi Viale, direttore del Dipartimento di Scienze Mediche Chirurgiche dell'Università di Bologna - si registrano 25mila decessi correlati alle infezioni da batteri multi resistenti e anche in Italia le percentuali di resistenza alle principali classi di antibiotici per i patogeni sotto sorveglianza si mantengono elevate".
Tanto che i decessi stimati in Italia sono oltre 10.000 ogni anno. Inoltre, aggiunge, Viale "negli ultimi anni la ricerca scientifica ha faticato a colmare questa lacuna".
Cefiderocol è una nuova terapia antibiotica in grado di dare copertura contro tutti i patogeni aerobi Gram-negativi considerati di priorità critica dall'Organizzazione Mondiale della Sanità (Oms), come Acinetobacter baumannii resistente ai carbapenemi e Pseudomonas aeruginosa.
"Poter disporre di un antibiotico di nuova generazione, da utilizzare in modo specifico e mirato su particolari ceppi resistenti ed efficace nel ridurre decessi e complicanze, può rappresentare davvero una svolta significativa per i pazienti", sottolinea Matteo Bassetti, direttore della Clinica Malattie Infettive del Policlinico San Martino di Genova.
Ad aver testato in via anticipata l'efficacia del nuovo antibiotico, proprio in pazienti in condizioni critiche e molti dei quali affetti da Covid-19, è stata l'Unità Operativa di Malattie Infettive dell'Azienda Ospedaliero-Universitaria Pisana. "La pandemia - spiega il direttore Francesco Menichetti - ha fatto emergere la gravità della 'crisi' degli antibiotici, che si sono rivelati inadeguati nel trattare persone con Sars-Cov-2 particolarmente esposte a infezioni batteriche secondarie".
Questo nuovo antibiotico "è stata una terapia di salvataggio cruciale per questi pazienti senza alternative terapeutiche", conclude Menichetti. Queste evidenze, sommate agli studi registrativi, confermano che la nuova cefalosporina possa essere un utile strumento per contrastare l'antimicrobicoresistenza. Ma da sola non basta. Serve, concludono gli esperti, una cooperazione territorio-ospedale più forte, per promuovere il corretto uso di antibiotici su più livelli, dal campo veterinario a quello ospedaliero.